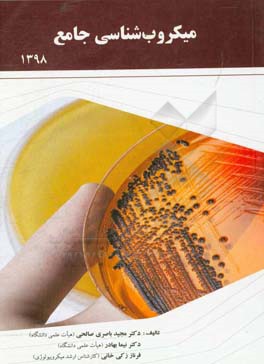
میکروب‌شناسی جامع

توضیحات محصول
مشخصات محصول
-
زبان
-
فارسی
-
وزن
-
573
-
کد دیوی
-
576
-
مکان انتشار
-
یزد - یزد
-
تعداد صفحه
-
382
-
زمان انتشار
-
1398
-
شابک
-
9786007415290
نظرات کاربران
- مرتب سازی بر اساس :
- نظر خریداران
- مفیدترین نظرات
- جدیدترین نظرات
هنوز نظری برای این محصول ثبت نشده است.

نظرات کاربران
برای ثبت نظر، از طریق دکمه ثبت نظر اقدام نمایید.
متوسط امتیازها
0.0